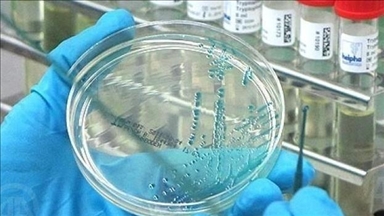
Afrique du Sud : Une hausse des cas de paludisme est enregistrée dans les régions touchées par les inondations

Afrique du Sud : Une hausse des cas de paludisme est enregistrée dans les régions touchées par les inondations
- Dans un communiqué de presse, le directeur du département de la Santé de Mpumalanga, Mandla Zwane, a alerté sur l’augmentation significative des cas de paludisme dans les zones sinistrées

Cape Town
AA/Capetown
En Afrique du Sud, une forte hausse des cas de paludisme a été enregistrée dans la province de Mpumalanga, la plus touchée par les inondations provoquées par de violentes pluies en janvier, ont annoncé les autorités sanitaires.
Dans un communiqué de presse, le directeur du département de la Santé de Mpumalanga, Mandla Zwane, a alerté sur l’augmentation significative des cas de paludisme dans les zones sinistrées.
« Par rapport à l’année dernière, nous constatons une hausse des cas cette année : en janvier dernier, nous avions recensé 69 cas, alors qu’aujourd’hui nous en comptons 314 », a-t-il déclaré.
Les autorités provinciales ont lancé une campagne de sensibilisation à l’échelle de l’État, appelant la population à redoubler de vigilance face aux moustiques et à porter des vêtements longs afin de réduire les risques de piqûres.
Les inondations survenues fin janvier en Afrique du Sud, à la suite de précipitations intenses, ont fait au moins 37 morts, selon les bilans officiels.
Le paludisme, une maladie causée par un parasite transmis par la piqûre de moustiques femelles du genre Anopheles, est qualifié par l’Organisation mondiale de la santé (OMS) de maladie « évitable et traitable ».
Également appelée « malaria », cette pathologie se manifeste notamment par de la fièvre, des frissons, des maux de tête, une fatigue intense, un jaunissement des yeux et de la peau, des convulsions et des difficultés respiratoires.
*Traduit du turc par Sanaa Amir
Seulement une partie des dépêches, que l'Agence Anadolu diffuse à ses abonnés via le Système de Diffusion interne (HAS), est diffusée sur le site de l'AA, de manière résumée. Contactez-nous s'il vous plaît pour vous abonner.